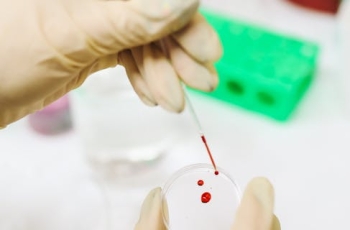

采血笔和采血针哪个好
采血笔和采血针哪个好?这是一个常见的问题,特别是对于需要长时间进行血液采集的医护人员而言。在过去的几十年里,采血针一直是主要的选择,但是随着科技的不断进步,采血笔也逐渐成为了一种热门的替代品。 我们来看看采血针的优点。采血针通常具有尖锐而细长的设计,可以迅速穿刺皮肤并进入血管。相比之下,采血笔则需要在皮肤上挤压一定的力气才能完成穿刺。由于采血针的结构较为简单,制作成本相对较低,因此它的价格通常也比较便宜。许多医护人员在使用采血针时已经非常熟练,因此使用起来相对较为方便。 采血针也存在一些缺点。首先,长时间使用采血针容易造成手部疲劳,对医护人员的手指和手腕造成额外的压力。其次,采血针穿刺后的止血…
查看更多